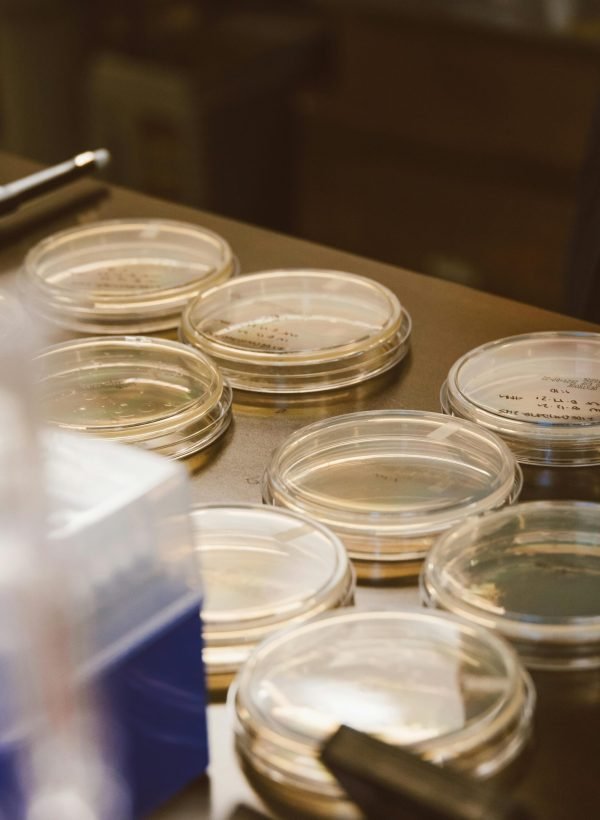
Close-up of glass Petri dishes in a laboratory, ideal for science and microbiology themes.

Innovación circular que revoluciona la nutrición animal
En CÍCCLICA biotransformamos residuos orgánicos en alimento premium de alto valor para el consumo animal, así como fertilizantes regenerativos y biomateriales
Contribuimos a la economía circular y el cuidado del medio ambiente
Somos pioneros en el occidente mexicano en la cría controlada y ética del díptero Hermetia illucens como agente de biotransformación. Nuestra tecnología convierte residuos orgánicos provenientes de la industria agrícola y de alimentos, en recursos de alto valor.
- Biotransformamos de manera eficiente diversos tipos de residuos agroalimentarios.
- Mantenemos estándares consistentes en la composición nutricional de nuestros productos y aseguramos la inocuidad en toda la cadena de producción.
- Ofrecemos trazabilidad completa desde el origen del residuo hasta el producto final.
- Adaptamos nuestros procesos según las necesidades específicas de diversos sectores industriales y requisitos nutricionales de los productos.
Nuestra meta es clara: cerrar el ciclo de la naturaleza y demostrar que es posible producir con impacto positivo en el medio ambiente.
Ciclo de Biotransformación
Aprovechamos el increíble poder de Hermetia illucens para convertir residuos orgánicos en productos valiosos.
Nuestros bioprocesos surgen de la aplicación de protocolos científicos rigurosos que garantizan la calidad y consistencia de nuestros productos

Recolección de materia orgánica
Recibimos residuos y subproductos orgánicos agroalimentarios provenientes de empresas y productores seleccionados

Biotransformación
Nuestros juveniles de Hermetia consumen y biotransforman masivamente estos residuos. Almacenando grandes cantidades de proteínas, grasas y minerales

Valorización
Los juveniles se cosechan y procesan para ser transformadas en nuestro alimento premium. Los restos del proceso, se convierten en un abono orgánico de alta calidad
Productos CÍCCLICA
Nutrición animal avanzada en su presentación más fresca: juveniles vivos de Hermetia que complementa y enriquece la dieta balanceada. Apto para aves, reptiles, anfibios y muchos otros animales.
- Rico en proteínas, minerales y ácidos grasos benéficos.
- Aumenta la salud y productividad animal.
Estimula instintos naturales de caza.
Alta digestibilidad y rendimiento.
Con nuestro proceso de secado obtenemos juveniles de Hermetia con una vida de anaquel extendida, que mantienen su calidad nutricional, sabor y una coloración impresionante.
Conservación prolongada sin perder nutrientes.
- Perfil de aminoácidos excepcional y mayor palatabilidad.
Fácil de dosificar y almacenar.
El subproducto de nuestra biotransformación lo convertimos en un optimizador de compostaje y biorremediador de suelos.
Con microorganismos y enzimas que acelera el compostaje en un 50% y suprime plagas de manera orgánica.
- Favorece la regeneración del suelo.
- 100% orgánico y seguro.
El resultado final de un ciclo virtuoso. Una composta de primera calidad, lista para enriquecer la tierra, fomentar la biodiversidad y completar el círculo de la economía circular.
- Composta orgánica que nutre tu suelo de forma natural.
- Rico en nutrientes y microbiota benéfica, mejora la salud de las plantas y promueve cultivos más fuertes y sostenibles.
Operamos en múltiples
sectores estratégicos




Ganadero, acuícola y mascotas
Nuestros productos representan alternativas sostenibles a las fuentes convencionales de proteína en la alimentación animal.



Agricultura sostenible
Con SoldyFrass y SoldyRoot contribuimos a la regeneración de suelos y al desarrollo de prácticas agrícolas circulares.

Investigación científica
Desarrollamos investigación científica orientadas a implementar nuevas aplicaciones biotecnológicas y desarrollo de nuevos productos.



Gestión de residuos
Ofrecemos una solución eficiente y escalable para la valorización de residuos orgánicos de la industria alimentaria primaria y de la transformación.
Conviértete en una empresa circular con CÍCCLICA
Biotransformación In-Company
Instalamos y operamos un sistema de biotransformación dentro de tu empresa, convirtiendo tus residuos orgánicos en productos útiles, sin que tengas que preocuparte por nada.
Recolección para la biotransformación
Si prefieres, recogemos tus residuos orgánicos y los transformamos en nuestros centros especializados, garantizando un manejo responsable y sostenible.
Testimonio de nuestros clientes
